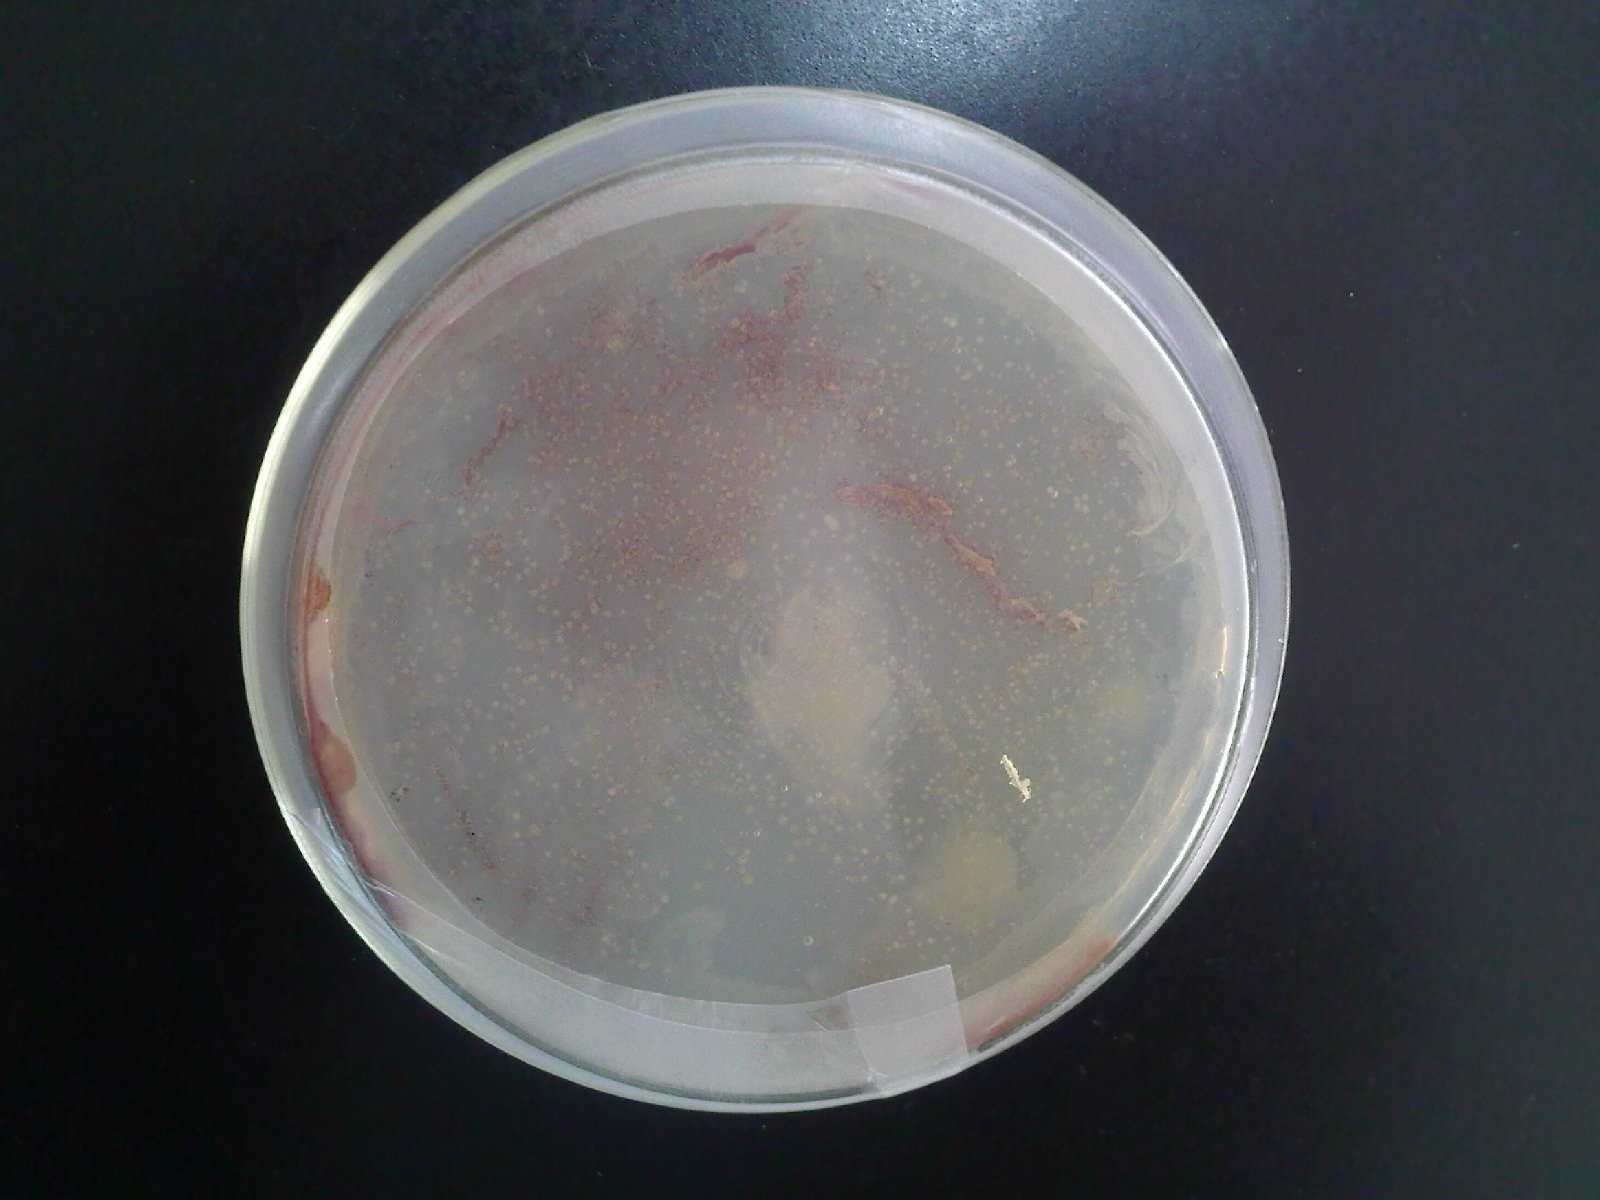
半固体培养基

半固体培养基图片

葡萄糖半固体培养基
图片尺寸502x460
固体半固体培养基液体培养基
图片尺寸531x471
半固体琼脂培养基 食品微生物 250g/瓶
图片尺寸800x800
半固体培养基
图片尺寸1600x1200
普通变形杆菌和奇异变形杆菌在gn增菌液中36℃±1℃培养18-24h后生长
图片尺寸1000x1181
半固体培养基的介绍
图片尺寸533x400
肺炎克雷伯氏菌在动力半固体培养基中无动力,延穿刺线生长.
图片尺寸1572x2042
科研实验试剂 半固体琼脂培养基 250g
图片尺寸800x800
gam半固体培养基
图片尺寸280x280
青岛海博半固体运送培养基hbpt0043产品规格40ml10
图片尺寸650x650
有鞭毛的细菌在半固体培养基内的生长现象
图片尺寸400x270
半固体琼脂
图片尺寸374x209
vp半固体琼脂培养基
图片尺寸475x434
培养ppt 液体培养基: 表面生长 均匀混浊生长 沉淀生长 半固体培养基
图片尺寸1080x810
环凯半固体琼脂培养基250g瓶
图片尺寸800x800
产品详情页-life technologies
图片尺寸650x600
用于观察微生物运动特征的半固体培养基
图片尺寸210x220
05葡萄糖肉汤培养基原理和使用方法
图片尺寸2976x3152
对于固体培养基ph监测,可使用平头电极或固液两用电极.
图片尺寸1080x1071
微生物在固体培养基上生长是否有延滞期
图片尺寸601x800